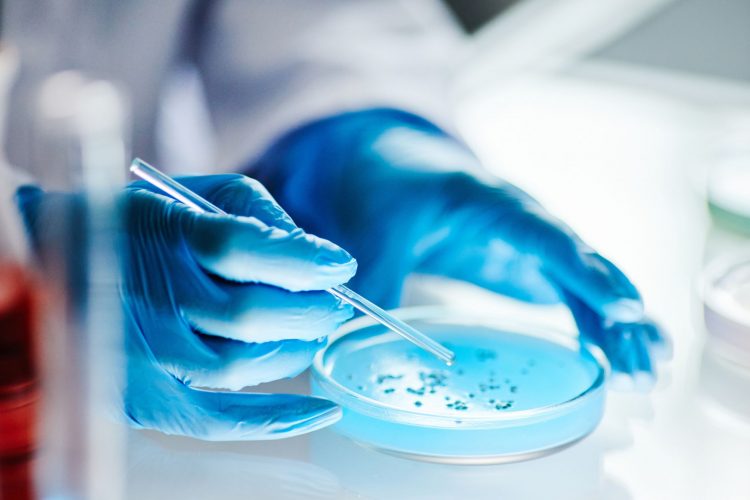

Ένα νέο αντιβιοτικό που έχει τη δυνατότητα να σώσει εκατομμύρια ζωές έχει εισέλθει στην τελευταία φάση των δοκιμών σε ανθρώπους.
Η ελβετική φαρμακευτική εταιρεία Roche ανακοίνωσε ότι θα προχωρήσει στο τρίτο και τελευταίο στάδιο των δοκιμών για τη δοκιμή ενός αντιβιοτικού κατά ενός κοινού βακτηρίου που προκαλεί σοβαρές νοσοκομειακές λοιμώξεις όπως πνευμονία και σήψη. Το αντιβιοτικό ζοσουραβαλπίνη, το οποίο αναπτύχθηκε από κοινού με το Πανεπιστήμιο Χάρβαρντ, πρόκειται να δοκιμαστεί έναντι του ανθεκτικού στα φάρμακα βακτηρίου acinetobacter baumannii.
Το αμερικανικό Κέντρο Ελέγχου και Πρόληψης Νοσημάτων (CDC) έχει χαρακτηρίσει το βακτήριο Acinetobacter baumannii ως μια πολύ σοβαρή απειλή για τη δημόσια υγεία. Αυτό το μικρόβιο έχει αναπτύξει μεγάλη αντοχή στα αντιβιοτικά και εδώ και πάνω από 50 χρόνια δεν έχει βρεθεί κάποιο νέο φάρμακο που να το αντιμετωπίζει αποτελεσματικά.
Η φαρμακευτική εταιρεία Roche ανακοίνωσε ότι ξεκινά μια μεγάλη διεθνή μελέτη, στην οποία θα συμμετέχουν περίπου 400 ασθενείς από όλο τον κόσμο. Οι ασθενείς αυτοί θα λάβουν είτε ένα νέο φάρμακο που ονομάζεται zosuarbalpin, είτε τη συνήθη θεραπεία. Αν το νέο φάρμακο αποδειχτεί αποτελεσματικό, θα αποτελέσει ένα μεγάλο βήμα στην καταπολέμηση των ανθεκτικών μικροβίων.
Ο Michael Lobritz, επικεφαλής του τομέα λοιμώξεων της Roche, τόνισε ότι:
«Στόχος μας είναι να προσφέρουμε καινοτόμες λύσεις απέναντι στην ανθεκτικότητα στα αντιβιοτικά, η οποία αποτελεί μια από τις μεγαλύτερες απειλές για τη δημόσια υγεία σήμερα.»
Από την πλευρά του, ο Larry Tsai από τη θυγατρική εταιρεία Genentech (που ανήκει στη Roche) επισήμανε ότι τα επικίνδυνα μικρόβια που αντιστέκονται στα φάρμακα υπάρχουν σε όλες τις χώρες του κόσμου. Συμπλήρωσε πως η επιστημονική έρευνα που γίνεται πάνω στο νέο φάρμακο μπορεί να μας βοηθήσει να κατανοήσουμε καλύτερα πώς λειτουργούν τα βακτήρια και ίσως να οδηγήσει στην ανακάλυψη και άλλων νέων φαρμάκων στο μέλλον.
Η ελπίδα είναι το νέο φάρμακο να πάρει έγκριση μέχρι το τέλος αυτής της δεκαετίας. Στο μεταξύ, η παγκόσμια ανάγκη για τέτοιες θεραπείες είναι τεράστια:
- Η σήψη (μια σοβαρή λοίμωξη που προκαλεί φλεγμονή σε όλο το σώμα) σκοτώνει περίπου 11 εκατομμύρια ανθρώπους κάθε χρόνο – δηλαδή ένας θάνατος κάθε 2,8 δευτερόλεπτα.
- Η πνευμονία που κολλά κανείς στην κοινότητα (δηλαδή εκτός νοσοκομείου) σκοτώνει 3 έως 4 εκατομμύρια ανθρώπους τον χρόνο, κυρίως ηλικιωμένους.
Πηγή: independent.co.uk